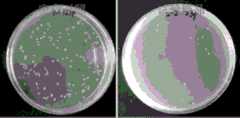

CN110917391A - Polypeptide modified sodium alginate/PVA hydrogel dressing and preparation method thereof - Google Patents
Polypeptide modified sodium alginate/PVA hydrogel dressing and preparation method thereofDownload PDFInfo
- Publication number
- CN110917391A CN110917391ACN201911362307.5ACN201911362307ACN110917391ACN 110917391 ACN110917391 ACN 110917391ACN 201911362307 ACN201911362307 ACN 201911362307ACN 110917391 ACN110917391 ACN 110917391A
- Authority
- CN
- China
- Prior art keywords
- sodium alginate
- polypeptide
- parts
- hydrogel dressing
- pva hydrogel
- Prior art date
- Legal status (The legal status is an assumption and is not a legal conclusion. Google has not performed a legal analysis and makes no representation as to the accuracy of the status listed.)
- Pending
Links
- IXPNQXFRVYWDDI-UHFFFAOYSA-N1-methyl-2,4-dioxo-1,3-diazinane-5-carboximidamideChemical classCN1CC(C(N)=N)C(=O)NC1=OIXPNQXFRVYWDDI-UHFFFAOYSA-N0.000titleclaimsabstractdescription52
- 229920001184polypeptidePolymers0.000titleclaimsabstractdescription40
- 108090000765processed proteins & peptidesProteins0.000titleclaimsabstractdescription40
- 102000004196processed proteins & peptidesHuman genes0.000titleclaimsabstractdescription40
- 239000000017hydrogelSubstances0.000titleclaimsabstractdescription33
- 238000002360preparation methodMethods0.000titleclaimsabstractdescription12
- 239000004372Polyvinyl alcoholSubstances0.000claimsabstractdescription39
- 229920002451polyvinyl alcoholPolymers0.000claimsabstractdescription39
- PEDCQBHIVMGVHV-UHFFFAOYSA-NGlycerineChemical compoundOCC(O)COPEDCQBHIVMGVHV-UHFFFAOYSA-N0.000claimsabstractdescription21
- XLYOFNOQVPJJNP-UHFFFAOYSA-NwaterChemical compoundOXLYOFNOQVPJJNP-UHFFFAOYSA-N0.000claimsabstractdescription18
- 238000000034methodMethods0.000claimsabstractdescription11
- UXVMQQNJUSDDNG-UHFFFAOYSA-LCalcium chlorideChemical compound[Cl-].[Cl-].[Ca+2]UXVMQQNJUSDDNG-UHFFFAOYSA-L0.000claimsabstractdescription7
- 238000002156mixingMethods0.000claimsabstractdescription6
- 238000004132cross linkingMethods0.000claimsabstractdescription4
- 239000008213purified waterSubstances0.000claimsabstractdescription4
- 239000001110calcium chlorideSubstances0.000claimsabstractdescription3
- 229910001628calcium chlorideInorganic materials0.000claimsabstractdescription3
- 150000002500ionsChemical class0.000claimsabstractdescription3
- 239000000661sodium alginateSubstances0.000claimsdescription27
- 235000010413sodium alginateNutrition0.000claimsdescription25
- 229940005550sodium alginateDrugs0.000claimsdescription25
- 239000000243solutionSubstances0.000claimsdescription15
- 239000000499gelSubstances0.000claimsdescription11
- 238000003756stirringMethods0.000claimsdescription9
- 238000005406washingMethods0.000claimsdescription6
- SXGZJKUKBWWHRA-UHFFFAOYSA-N2-(N-morpholiniumyl)ethanesulfonateChemical compound[O-]S(=O)(=O)CC[NH+]1CCOCC1SXGZJKUKBWWHRA-UHFFFAOYSA-N0.000claimsdescription5
- 238000002791soakingMethods0.000claimsdescription5
- FPQQSJJWHUJYPU-UHFFFAOYSA-N3-(dimethylamino)propyliminomethylidene-ethylazanium;chlorideChemical compoundCl.CCN=C=NCCCN(C)CFPQQSJJWHUJYPU-UHFFFAOYSA-N0.000claimsdescription4
- 108010039918PolylysineProteins0.000claimsdescription4
- 238000005520cutting processMethods0.000claimsdescription4
- 239000008367deionised waterSubstances0.000claimsdescription4
- 229910021641deionized waterInorganic materials0.000claimsdescription4
- 238000001035dryingMethods0.000claimsdescription4
- 238000004806packaging method and processMethods0.000claimsdescription4
- NQTADLQHYWFPDB-UHFFFAOYSA-NN-HydroxysuccinimideChemical compoundON1C(=O)CCC1=ONQTADLQHYWFPDB-UHFFFAOYSA-N0.000claimsdescription3
- 239000007853buffer solutionSubstances0.000claimsdescription3
- 238000004108freeze dryingMethods0.000claimsdescription3
- 238000007710freezingMethods0.000claimsdescription3
- 230000008014freezingEffects0.000claimsdescription3
- 239000007864aqueous solutionSubstances0.000claimsdescription2
- 230000001954sterilising effectEffects0.000claimsdescription2
- 238000010257thawingMethods0.000claimsdescription2
- 206010052428WoundDiseases0.000abstractdescription10
- 208000027418Wounds and injuryDiseases0.000abstractdescription10
- 230000001684chronic effectEffects0.000abstractdescription5
- 230000029663wound healingEffects0.000abstractdescription5
- 230000023597hemostasisEffects0.000abstractdescription3
- 238000010521absorption reactionMethods0.000abstractdescription2
- 239000000227bioadhesiveSubstances0.000abstractdescription2
- 230000003115biocidal effectEffects0.000abstractdescription2
- 210000000416exudates and transudateAnatomy0.000abstractdescription2
- 230000014759maintenance of locationEffects0.000abstractdescription2
- 238000012360testing methodMethods0.000description9
- 239000000523sampleSubstances0.000description8
- 239000004744fabricSubstances0.000description5
- 238000000338in vitroMethods0.000description5
- FHVDTGUDJYJELY-UHFFFAOYSA-N6-{[2-carboxy-4,5-dihydroxy-6-(phosphanyloxy)oxan-3-yl]oxy}-4,5-dihydroxy-3-phosphanyloxane-2-carboxylic acidChemical compoundO1C(C(O)=O)C(P)C(O)C(O)C1OC1C(C(O)=O)OC(OP)C(O)C1OFHVDTGUDJYJELY-UHFFFAOYSA-N0.000description4
- 210000004027cellAnatomy0.000description4
- 238000010186stainingMethods0.000description4
- 241000894006BacteriaSpecies0.000description3
- IAZDPXIOMUYVGZ-UHFFFAOYSA-NDimethylsulphoxideChemical compoundCS(C)=OIAZDPXIOMUYVGZ-UHFFFAOYSA-N0.000description3
- 230000001580bacterial effectEffects0.000description3
- 239000006285cell suspensionSubstances0.000description3
- 231100000135cytotoxicityToxicity0.000description3
- 230000003013cytotoxicityEffects0.000description3
- 231100000263cytotoxicity testToxicity0.000description3
- 230000000694effectsEffects0.000description3
- 239000013642negative controlSubstances0.000description3
- 239000013641positive controlSubstances0.000description3
- 238000005303weighingMethods0.000description3
- 108091003079Bovine Serum AlbuminProteins0.000description2
- 241000282414Homo sapiensSpecies0.000description2
- FAPWRFPIFSIZLT-UHFFFAOYSA-MSodium chlorideChemical compound[Na+].[Cl-]FAPWRFPIFSIZLT-UHFFFAOYSA-M0.000description2
- 229940072056alginateDrugs0.000description2
- 235000010443alginic acidNutrition0.000description2
- 229920000615alginic acidPolymers0.000description2
- 230000000844anti-bacterial effectEffects0.000description2
- 238000006243chemical reactionMethods0.000description2
- 238000012258culturingMethods0.000description2
- 238000011161developmentMethods0.000description2
- 230000018109developmental processEffects0.000description2
- 206010012601diabetes mellitusDiseases0.000description2
- 239000012153distilled waterSubstances0.000description2
- 239000001963growth mediumSubstances0.000description2
- 229910052739hydrogenInorganic materials0.000description2
- 239000001257hydrogenSubstances0.000description2
- 238000002386leachingMethods0.000description2
- 239000007788liquidSubstances0.000description2
- 239000000203mixtureSubstances0.000description2
- 230000001737promoting effectEffects0.000description2
- 239000000725suspensionSubstances0.000description2
- 208000008960Diabetic footDiseases0.000description1
- 241000588724Escherichia coliSpecies0.000description1
- 208000031737Tissue AdhesionsDiseases0.000description1
- 238000005411Van der Waals forceMethods0.000description1
- 206010048038Wound infectionDiseases0.000description1
- 238000002835absorbanceMethods0.000description1
- 230000032683agingEffects0.000description1
- 238000002266amputationMethods0.000description1
- 230000003385bacteriostatic effectEffects0.000description1
- 230000009286beneficial effectEffects0.000description1
- 230000007227biological adhesionEffects0.000description1
- 210000004748cultured cellAnatomy0.000description1
- 238000002784cytotoxicity assayMethods0.000description1
- 238000007865dilutingMethods0.000description1
- 238000004043dyeingMethods0.000description1
- 230000009881electrostatic interactionEffects0.000description1
- 238000011156evaluationMethods0.000description1
- 238000002474experimental methodMethods0.000description1
- 239000012091fetal bovine serumSubstances0.000description1
- 239000012894fetal calf serumSubstances0.000description1
- 210000002950fibroblastAnatomy0.000description1
- 125000002887hydroxy groupChemical group[H]O*0.000description1
- 230000005764inhibitory processEffects0.000description1
- 230000003993interactionEffects0.000description1
- 238000002372labellingMethods0.000description1
- 238000012986modificationMethods0.000description1
- 230000004048modificationEffects0.000description1
- 230000003020moisturizing effectEffects0.000description1
- 231100000252nontoxicToxicity0.000description1
- 230000003000nontoxic effectEffects0.000description1
- 239000003973paintSubstances0.000description1
- 238000002464physical blendingMethods0.000description1
- 229920000642polymerPolymers0.000description1
- 230000008569processEffects0.000description1
- 230000035755proliferationEffects0.000description1
- 239000002994raw materialSubstances0.000description1
- 230000004044responseEffects0.000description1
- 239000012488sample solutionSubstances0.000description1
- 239000011780sodium chlorideSubstances0.000description1
- 239000000126substanceSubstances0.000description1
- 230000008961swellingEffects0.000description1
- 231100000419toxicityToxicity0.000description1
- 230000001988toxicityEffects0.000description1
- 238000004804windingMethods0.000description1
Images
Classifications
- A—HUMAN NECESSITIES
- A61—MEDICAL OR VETERINARY SCIENCE; HYGIENE
- A61L—METHODS OR APPARATUS FOR STERILISING MATERIALS OR OBJECTS IN GENERAL; DISINFECTION, STERILISATION OR DEODORISATION OF AIR; CHEMICAL ASPECTS OF BANDAGES, DRESSINGS, ABSORBENT PADS OR SURGICAL ARTICLES; MATERIALS FOR BANDAGES, DRESSINGS, ABSORBENT PADS OR SURGICAL ARTICLES
- A61L26/00—Chemical aspects of, or use of materials for, wound dressings or bandages in liquid, gel or powder form
- A61L26/0061—Use of materials characterised by their function or physical properties
- A61L26/008—Hydrogels or hydrocolloids
- A—HUMAN NECESSITIES
- A61—MEDICAL OR VETERINARY SCIENCE; HYGIENE
- A61L—METHODS OR APPARATUS FOR STERILISING MATERIALS OR OBJECTS IN GENERAL; DISINFECTION, STERILISATION OR DEODORISATION OF AIR; CHEMICAL ASPECTS OF BANDAGES, DRESSINGS, ABSORBENT PADS OR SURGICAL ARTICLES; MATERIALS FOR BANDAGES, DRESSINGS, ABSORBENT PADS OR SURGICAL ARTICLES
- A61L26/00—Chemical aspects of, or use of materials for, wound dressings or bandages in liquid, gel or powder form
- A61L26/0009—Chemical aspects of, or use of materials for, wound dressings or bandages in liquid, gel or powder form containing macromolecular materials
- A61L26/0014—Chemical aspects of, or use of materials for, wound dressings or bandages in liquid, gel or powder form containing macromolecular materials obtained by reactions only involving carbon-to-carbon unsaturated bonds
- A—HUMAN NECESSITIES
- A61—MEDICAL OR VETERINARY SCIENCE; HYGIENE
- A61L—METHODS OR APPARATUS FOR STERILISING MATERIALS OR OBJECTS IN GENERAL; DISINFECTION, STERILISATION OR DEODORISATION OF AIR; CHEMICAL ASPECTS OF BANDAGES, DRESSINGS, ABSORBENT PADS OR SURGICAL ARTICLES; MATERIALS FOR BANDAGES, DRESSINGS, ABSORBENT PADS OR SURGICAL ARTICLES
- A61L26/00—Chemical aspects of, or use of materials for, wound dressings or bandages in liquid, gel or powder form
- A61L26/0009—Chemical aspects of, or use of materials for, wound dressings or bandages in liquid, gel or powder form containing macromolecular materials
- A61L26/0023—Polysaccharides
- A—HUMAN NECESSITIES
- A61—MEDICAL OR VETERINARY SCIENCE; HYGIENE
- A61L—METHODS OR APPARATUS FOR STERILISING MATERIALS OR OBJECTS IN GENERAL; DISINFECTION, STERILISATION OR DEODORISATION OF AIR; CHEMICAL ASPECTS OF BANDAGES, DRESSINGS, ABSORBENT PADS OR SURGICAL ARTICLES; MATERIALS FOR BANDAGES, DRESSINGS, ABSORBENT PADS OR SURGICAL ARTICLES
- A61L26/00—Chemical aspects of, or use of materials for, wound dressings or bandages in liquid, gel or powder form
- A61L26/0061—Use of materials characterised by their function or physical properties
- A61L26/0066—Medicaments; Biocides
- C—CHEMISTRY; METALLURGY
- C08—ORGANIC MACROMOLECULAR COMPOUNDS; THEIR PREPARATION OR CHEMICAL WORKING-UP; COMPOSITIONS BASED THEREON
- C08B—POLYSACCHARIDES; DERIVATIVES THEREOF
- C08B37/00—Preparation of polysaccharides not provided for in groups C08B1/00 - C08B35/00; Derivatives thereof
- C08B37/006—Heteroglycans, i.e. polysaccharides having more than one sugar residue in the main chain in either alternating or less regular sequence; Gellans; Succinoglycans; Arabinogalactans; Tragacanth or gum tragacanth or traganth from Astragalus; Gum Karaya from Sterculia urens; Gum Ghatti from Anogeissus latifolia; Derivatives thereof
- C08B37/0084—Guluromannuronans, e.g. alginic acid, i.e. D-mannuronic acid and D-guluronic acid units linked with alternating alpha- and beta-1,4-glycosidic bonds; Derivatives thereof, e.g. alginates
- A—HUMAN NECESSITIES
- A61—MEDICAL OR VETERINARY SCIENCE; HYGIENE
- A61L—METHODS OR APPARATUS FOR STERILISING MATERIALS OR OBJECTS IN GENERAL; DISINFECTION, STERILISATION OR DEODORISATION OF AIR; CHEMICAL ASPECTS OF BANDAGES, DRESSINGS, ABSORBENT PADS OR SURGICAL ARTICLES; MATERIALS FOR BANDAGES, DRESSINGS, ABSORBENT PADS OR SURGICAL ARTICLES
- A61L2300/00—Biologically active materials used in bandages, wound dressings, absorbent pads or medical devices
- A61L2300/20—Biologically active materials used in bandages, wound dressings, absorbent pads or medical devices containing or releasing organic materials
- A61L2300/252—Polypeptides, proteins, e.g. glycoproteins, lipoproteins, cytokines
- A—HUMAN NECESSITIES
- A61—MEDICAL OR VETERINARY SCIENCE; HYGIENE
- A61L—METHODS OR APPARATUS FOR STERILISING MATERIALS OR OBJECTS IN GENERAL; DISINFECTION, STERILISATION OR DEODORISATION OF AIR; CHEMICAL ASPECTS OF BANDAGES, DRESSINGS, ABSORBENT PADS OR SURGICAL ARTICLES; MATERIALS FOR BANDAGES, DRESSINGS, ABSORBENT PADS OR SURGICAL ARTICLES
- A61L2300/00—Biologically active materials used in bandages, wound dressings, absorbent pads or medical devices
- A61L2300/40—Biologically active materials used in bandages, wound dressings, absorbent pads or medical devices characterised by a specific therapeutic activity or mode of action
- A61L2300/418—Agents promoting blood coagulation, blood-clotting agents, embolising agents
Landscapes
- Health & Medical Sciences (AREA)
- Chemical & Material Sciences (AREA)
- Life Sciences & Earth Sciences (AREA)
- General Health & Medical Sciences (AREA)
- Engineering & Computer Science (AREA)
- Materials Engineering (AREA)
- Veterinary Medicine (AREA)
- Animal Behavior & Ethology (AREA)
- Public Health (AREA)
- Epidemiology (AREA)
- Chemical Kinetics & Catalysis (AREA)
- Dispersion Chemistry (AREA)
- Molecular Biology (AREA)
- Biochemistry (AREA)
- Medicinal Chemistry (AREA)
- Polymers & Plastics (AREA)
- Organic Chemistry (AREA)
- Materials For Medical Uses (AREA)
- Medicinal Preparation (AREA)
Abstract
Description
Technical Field
The invention relates to the technical field of medical dressing preparation, in particular to a polypeptide modified sodium alginate/PVA hydrogel dressing and a preparation method thereof.
Background
With the continuous rise of the living standard of human beings and the development of aging population, the prevalence rate of diabetes at home and abroad is increased year by year, the diabetic foot is a common complication of a diabetic patient, a wound is difficult to heal and easy to infect, amputation or death can be caused seriously, great inconvenience and pain are brought to the life of the patient, and the development of the hydrogel wound dressing suitable for chronic wound care is an effective way for relieving the pain of the patient.
The hydrogel is a polymer which has a three-dimensional network structure and is insoluble and capable of swelling in water and retaining a large amount of water, and is formed by mutual crosslinking through covalent bonds, hydrogen bonds or van der waals forces. The hydrogel contains a large amount of water, is similar to human tissues, has excellent biocompatibility, and is widely applied to the field of medical dressings. The polyvinyl alcohol is safe and nontoxic, and in the process of forming gel, the hydrogen bond of hydroxyl groups among polyvinyl alcohol molecular chains can form a winding structure, so that the gel has excellent mechanical properties. The polyvinyl alcohol and the alginate are combined to prepare the hydrogel, so that the hydrogel has the effects of moisturizing and promoting wound healing. The natural polypeptide and the tissue have ionic electrostatic interaction and good tissue adhesion, and the biological adhesion of the gel can be enhanced and the broad-spectrum bacteriostasis effect can be achieved by introducing the natural polypeptide and the tissue into a gel system in a physical blending or grafting manner.
Disclosure of Invention
The invention aims to provide a polypeptide modified sodium alginate/PVA hydrogel dressing suitable for chronic wound care, which is applied to chronic wound care, more effectively prevents wound infection and promotes wound healing.
In order to solve the technical problems, the invention provides the following technical scheme: the paint comprises the following components in parts by weight: 1-3 parts of sodium alginate derivative, 6-9 parts of polyvinyl alcohol, 5-10 parts of glycerol, 0.1-5 parts of calcium chloride and 73-88 parts of purified water.
The preparation method of the polypeptide modified sodium alginate/PVA hydrogel dressing comprises the following steps:
s1: dispersing a certain amount of sodium alginate polypeptide derivative in glycerol, adding deionized water, and stirring for dissolving uniformly.
S2, preparing a polyvinyl alcohol aqueous solution, dissolving in a water bath at 85 ℃, mixing with S1, pouring into a mold, and repeatedly freezing and thawing for three times.
S3: and (4) soaking the gel obtained in the step (S2) in a calcium chloride solution, and then washing, drying, cutting, packaging and sterilizing to obtain the double-network interpenetrating sodium alginate polypeptide derivative/PVA hydrogel dressing.
The preparation method of the sodium alginate polypeptide derivative comprises the following steps:
s1: sodium alginate was dissolved in 2- (N-morpholino) ethanesulfonic acid (MES) buffer solution, and 1- (3-dimethylaminopropyl) -3-ethylcarbodiimide hydrochloride and N-hydroxysuccinimide were added thereto and stirred at room temperature for 18 hours.
And S2, adding epsilon-polylysine, continuing stirring for 2 hours, dialyzing for 3 days, and freeze-drying to obtain the sodium alginate polypeptide derivative.
The invention has the beneficial effects that:
(1) the polypeptide modified sodium alginate/PVA hydrogel dressing dual-network interpenetrating gel dressing prepared by the method has stable performance and can be stored at normal temperature.
(2) The polypeptide modified sodium alginate/PVA hydrogel dressing has the advantages that the polypeptide is introduced through chemical grafting, the biological adhesiveness of the gel is enhanced, the bacterial growth is inhibited, the wound is adhered, and the hemostasis is accelerated.
(3) The alginate used as the raw material of the polypeptide modified sodium alginate/PVA hydrogel dressing has good biocompatibility, has the effect of promoting wound healing and has good biocompatibility.
(4) The polypeptide modified sodium alginate/PVA double-network interpenetrating hydrogel dressing suitable for chronic wound care is prepared by blending the polypeptide modified sodium alginate and a PVA solution and combining a repeated freeze-thaw method and an ion crosslinking method, and has the functions of bioadhesive hemostasis, broad-spectrum antibiosis, wound exudate absorption, moisture retention and wound healing promotion.
Drawings
FIG. 1 is a comparison graph of bacteriostatic test results.
Detailed Description
The first embodiment is as follows:
a preparation method of a polypeptide modified sodium alginate/PVA hydrogel dressing comprises the following steps:
s1: weighing 2.0g of sodium alginate polypeptide derivative, dispersing in 5mL of glycerol, adding 30mL of deionized water, and stirring uniformly to prepare a sodium alginate polypeptide derivative solution with a certain concentration.
S2, 8.0g of polyvinyl alcohol is weighed, 70mL of distilled water is added, and the mixture is dissolved uniformly in a water bath at 85 ℃. At room temperature, the sodium alginate polypeptide derivative solution and the polyvinyl alcohol solution are mixed evenly and poured into a mould. The mixture was then frozen in a refrigerator for 6 hours and thawed at room temperature for 2 hours, repeated three times.
S3: and (3) soaking the gel obtained in the step (S2) in a calcium chloride solution, and then washing, drying, cutting, packaging and completely killing to obtain the double-network interpenetrating sodium alginate polypeptide derivative/PVA hydrogel dressing.
Example two:
a preparation method of a polypeptide modified sodium alginate/PVA hydrogel dressing comprises the following steps:
s1: 3.0g of sodium alginate polypeptide derivative is weighed and dispersed in 5mL of glycerol, 30mL of deionized water is added and stirred uniformly, and sodium alginate polypeptide derivative solution with certain concentration is prepared.
S2, weighing 7.0g of polyvinyl alcohol, adding 70mL of distilled water, and dissolving uniformly in a water bath at 85 ℃. At room temperature, the sodium alginate polypeptide derivative solution and the polyvinyl alcohol solution are mixed evenly, poured into a mold, then placed into a refrigerator for freezing for 8 hours, unfrozen at room temperature for 3 hours, and repeated for three times.
S3: and (3) soaking the gel obtained in the step (S2) in a calcium chloride solution, and then washing, drying, cutting, packaging and completely killing to obtain the double-network interpenetrating sodium alginate polypeptide derivative/PVA hydrogel dressing.
Example three:
the preparation method of the sodium alginate polypeptide derivative comprises the following steps:
s1: preparing 100mL of 2- (N-morpholino) ethanesulfonic acid (MES) buffer solution with the concentration of 0.25mol/L, dropwise adding sodium chloride solution to adjust the pH value to 6.5, adding 1.0g of sodium alginate, and stirring until the sodium alginate is fully dissolved.
S2 adding 0.70g of 1- (3-dimethylaminopropyl) -3-ethylcarbodiimide hydrochloride (EDC) and 0.26g of N-hydroxysuccinimide, stirring at normal temperature for 18 hours, adding epsilon-polylysine, continuing stirring for 2 hours, dialyzing with purified water for three days, and freeze-drying to obtain the sodium alginate polypeptide derivative.
Example four:
prepared by the inventionSodium alginate derivatives andthe hydrogel dressings were separately subjected to in vitro cytotoxicity tests.
Reference is made to GB/T16886.5-2017 medical device biology evaluation part five: in vitro cytotoxicity assay methods.
Cell line: mouse fibroblast L929
Negative control group: 2% fetal bovine serum culture medium
Positive control group: 10% DMSO solution
Test groups: adding 2 percent fetal calf serum culture medium leaching liquor according to the proportion of 0.1g/ml of the sample mass, and shaking at the constant temperature of 37 ℃ for 24 +/-1 h.
Digesting cultured cells with vigorous growth for 48-72 h to obtain the cell with density of 1.5 × 104Inoculating the cell suspension of each cell/ml into a 96-well plate, adding 100 mu L of the cell suspension into each well, and placing the cell suspension in 5% CO2The culture was carried out in an incubator at 37 ℃ for 24 hours.
Discarding the original culture solution, adding 200 μ L negative control solution, positive control solution, and sample solution, placing 5 holes in each group, and placing in 5% CO2The culture was carried out in an incubator at 37 ℃ for 48 hours. Adding 15 mu LMTT solution and 5% CO into each hole2Culturing for 4h at 37 ℃ in an incubator, discarding the culture solution, adding 150 mu LDMSO respectively, shaking for 10min, detecting the absorbance at 490nm on an enzyme-labeling instrument, calculating the increment rate, and grading the in-vitro cytotoxicity reaction according to the table 1. The test results are shown in table 2.
TABLE 1 in vitro cytotoxicity response ranking
| Toxicity rating (grade) | 0 | 1 | 2 | 3 | 4 |
| Relative proliferation Rate (%) | ≥100 | 80-99 | 50-79 | 30-49 | 0-29 |
TABLE 2 in vitro cytotoxicity test results
As can be seen from Table 3, willSodium alginate derivatives andthe leaching liquor of the hydrogel dressing is used for culturing cells for 2 days respectively, and the cytotoxicity reaction grading is 1 grade, which shows that the sodium alginate derivative and the hydrogel dressing both have good biocompatibility.
Example five:
the polypeptide modified sodium alginate/PVA hydrogel dressing prepared by the invention is subjected to a bacteriostasis test.
The quantitative bacteriostasis test is carried out according to the carrier soaking method specified in WS/T650-2019.
Washing 24h fresh slant culture of test bacterium Escherichia coli with PBS, and diluting to 5.0 × 106CFU/mL~5.0×107CFU/mL bacterial suspension is ready for use. 10 mul of the bacterial suspension was applied by drop-dyeing to sterilized plain cloth pieces (10 mm. times.10 mm) and dried at 36 ℃. + -. 1 ℃ for use.
Weighing a sample according to the amount of 5 g/piece, placing the sample in a sterile plate, placing the sterile plate in a water bath at 20 +/-1 ℃ for 5min, taking a bacteria-staining cloth piece by using a sterile forceps, completely immersing the cloth piece in the sample, immediately timing, respectively taking out the bacteria-staining cloth piece, placing the bacteria-staining cloth piece into 5.0 mL PBS test tubes after 6 hours of interaction between a bacteria-staining carrier and the sample, uniformly mixing, oscillating, washing test bacteria, respectively absorbing 1.0 mL sample liquid, determining the number of viable bacteria according to a viable bacteria culture counting method, and inoculating 2 plates in each tube of sample liquid. The same batch of PBS was taken as negative control. All test samples and control samples were incubated at 36 ℃. + -. 1 ℃ for 48h to observe the results. The experiment was repeated 3 times, and the inhibition rate was calculated, and the experimental results are shown in fig. 1.
As can be seen from FIG. 1, compared with the blank group, the polypeptide-modified sodium alginate/PVA hydrogel dressing prepared by the invention has antibacterial activity, and the average antibacterial rate is 79.9%.
While specific embodiments of the present invention have been described above, the present invention is not limited to the above embodiments, and various modifications can be made within the scope of the technical gist of the present invention in the technical field of the present invention, as long as the general knowledge is grasped.
Claims (5)
1. The polypeptide modified sodium alginate/PVA hydrogel dressing is characterized by comprising the following components in parts by weight: 1-3 parts of sodium alginate derivative, 6-9 parts of polyvinyl alcohol, 5-10 parts of glycerol, 0.1-5 parts of calcium chloride and 73-88 parts of purified water.
2. The polypeptide-modified sodium alginate/PVA hydrogel dressing as claimed in claim 1, wherein the polypeptide-modified sodium alginate/PVA hydrogel dressing is prepared by mixing a sodium alginate polypeptide derivative with polyvinyl alcohol, and combining a repeated freeze-thaw method and an ion crosslinking method.
3. The polypeptide-modified sodium alginate/PVA hydrogel dressing as claimed in claim 2, wherein the sodium alginate polypeptide derivative is obtained by grafting sodium alginate with epsilon-polylysine.
4. The polypeptide-modified sodium alginate/PVA hydrogel dressing as claimed in claim 3, wherein the preparation method of the sodium alginate polypeptide derivative comprises the following steps:
s1: dissolving sodium alginate in 2- (N-morpholino) ethanesulfonic acid buffer solution, adding 1- (3-dimethylaminopropyl) -3-ethylcarbodiimide hydrochloride and N-hydroxysuccinimide, and stirring at normal temperature for 18 hours;
and S2, adding epsilon-polylysine, continuing stirring for 2 hours, dialyzing for 3 days, and freeze-drying to obtain the sodium alginate polypeptide derivative.
5. The preparation method of the polypeptide-modified sodium alginate/PVA hydrogel dressing as claimed in any one of claims 1 to 4, characterized by comprising the following steps:
s1: dispersing a certain amount of sodium alginate polypeptide derivative in glycerol, adding deionized water, and stirring for dissolving uniformly;
s2, preparing a polyvinyl alcohol aqueous solution, dissolving in a water bath at 85 ℃, blending with S1, pouring into a mold, and repeatedly freezing and thawing for three times to obtain gel;
s3: and (4) soaking the gel obtained in the step (S2) in a calcium chloride solution, and then washing, drying, cutting, packaging and sterilizing to obtain the double-network interpenetrating sodium alginate polypeptide derivative/PVA hydrogel dressing.
Priority Applications (1)
| Application Number | Priority Date | Filing Date | Title |
|---|---|---|---|
| CN201911362307.5ACN110917391A (en) | 2019-12-26 | 2019-12-26 | Polypeptide modified sodium alginate/PVA hydrogel dressing and preparation method thereof |
Applications Claiming Priority (1)
| Application Number | Priority Date | Filing Date | Title |
|---|---|---|---|
| CN201911362307.5ACN110917391A (en) | 2019-12-26 | 2019-12-26 | Polypeptide modified sodium alginate/PVA hydrogel dressing and preparation method thereof |
Publications (1)
| Publication Number | Publication Date |
|---|---|
| CN110917391Atrue CN110917391A (en) | 2020-03-27 |
Family
ID=69862131
Family Applications (1)
| Application Number | Title | Priority Date | Filing Date |
|---|---|---|---|
| CN201911362307.5APendingCN110917391A (en) | 2019-12-26 | 2019-12-26 | Polypeptide modified sodium alginate/PVA hydrogel dressing and preparation method thereof |
Country Status (1)
| Country | Link |
|---|---|
| CN (1) | CN110917391A (en) |
Cited By (4)
| Publication number | Priority date | Publication date | Assignee | Title |
|---|---|---|---|---|
| CN114425098A (en)* | 2022-02-08 | 2022-05-03 | 褚二喜 | Antibacterial and anti-inflammatory medical gel and preparation method thereof |
| CN114796620A (en)* | 2022-04-24 | 2022-07-29 | 广东顺德工业设计研究院(广东顺德创新设计研究院) | Interpenetrating network hydrogel used as medical implant material and preparation method and application thereof |
| CN115634314A (en)* | 2022-10-28 | 2023-01-24 | 广州贝奥吉因生物科技股份有限公司 | Non-supported bone repair gel microsphere and preparation method thereof |
| CN118806980A (en)* | 2024-09-18 | 2024-10-22 | 吉林省海卓生物科技有限公司 | Antibacterial modified sodium alginate aerogel hemostatic dressing and preparation method thereof |
Citations (9)
| Publication number | Priority date | Publication date | Assignee | Title |
|---|---|---|---|---|
| CN101426530A (en)* | 2004-05-12 | 2009-05-06 | 梅迪沃什有限公司 | Wound healing polymer compositions and methods for use thereof |
| US20100285094A1 (en)* | 2006-04-20 | 2010-11-11 | University Of Utah Research Foundation | Polymeric compositions and methods of making and using thereof |
| CN102078636A (en)* | 2011-01-07 | 2011-06-01 | 中山大学孙逸仙纪念医院 | Hydrogel dressing containing recombinant human epidermal growth factor and preparation method and application thereof |
| CN106390185A (en)* | 2016-12-02 | 2017-02-15 | 上海其胜生物制剂有限公司 | Preparation method of biological mimetic tissue adhesive |
| CN106512064A (en)* | 2017-01-12 | 2017-03-22 | 广东泰宝医疗器械技术研究院有限公司 | Skin wound dressing with antimicrobial property and preparation method of skin wound dressing |
| CN109260508A (en)* | 2018-08-08 | 2019-01-25 | 华南理工大学 | A kind of polyvinyl alcohol/Sodium Alginate Hydrogel Films preparation method with promotion skin fibroblasts proliferative functionality |
| CN109503864A (en)* | 2018-12-04 | 2019-03-22 | 上海其胜生物制剂有限公司 | One kind has the preparation method of the injection aquagel of cohesion enhancing characteristic |
| CN109701069A (en)* | 2019-01-29 | 2019-05-03 | 北京化工大学 | A kind of antibacterial tissue adhesive and preparation method thereof |
| CN109731130A (en)* | 2018-11-14 | 2019-05-10 | 华中科技大学同济医学院附属协和医院 | A method for preparing hydrogel wound dressings by low-temperature bio-3D printing technology |
- 2019
- 2019-12-26CNCN201911362307.5Apatent/CN110917391A/enactivePending
Patent Citations (9)
| Publication number | Priority date | Publication date | Assignee | Title |
|---|---|---|---|---|
| CN101426530A (en)* | 2004-05-12 | 2009-05-06 | 梅迪沃什有限公司 | Wound healing polymer compositions and methods for use thereof |
| US20100285094A1 (en)* | 2006-04-20 | 2010-11-11 | University Of Utah Research Foundation | Polymeric compositions and methods of making and using thereof |
| CN102078636A (en)* | 2011-01-07 | 2011-06-01 | 中山大学孙逸仙纪念医院 | Hydrogel dressing containing recombinant human epidermal growth factor and preparation method and application thereof |
| CN106390185A (en)* | 2016-12-02 | 2017-02-15 | 上海其胜生物制剂有限公司 | Preparation method of biological mimetic tissue adhesive |
| CN106512064A (en)* | 2017-01-12 | 2017-03-22 | 广东泰宝医疗器械技术研究院有限公司 | Skin wound dressing with antimicrobial property and preparation method of skin wound dressing |
| CN109260508A (en)* | 2018-08-08 | 2019-01-25 | 华南理工大学 | A kind of polyvinyl alcohol/Sodium Alginate Hydrogel Films preparation method with promotion skin fibroblasts proliferative functionality |
| CN109731130A (en)* | 2018-11-14 | 2019-05-10 | 华中科技大学同济医学院附属协和医院 | A method for preparing hydrogel wound dressings by low-temperature bio-3D printing technology |
| CN109503864A (en)* | 2018-12-04 | 2019-03-22 | 上海其胜生物制剂有限公司 | One kind has the preparation method of the injection aquagel of cohesion enhancing characteristic |
| CN109701069A (en)* | 2019-01-29 | 2019-05-03 | 北京化工大学 | A kind of antibacterial tissue adhesive and preparation method thereof |
Cited By (6)
| Publication number | Priority date | Publication date | Assignee | Title |
|---|---|---|---|---|
| CN114425098A (en)* | 2022-02-08 | 2022-05-03 | 褚二喜 | Antibacterial and anti-inflammatory medical gel and preparation method thereof |
| CN114796620A (en)* | 2022-04-24 | 2022-07-29 | 广东顺德工业设计研究院(广东顺德创新设计研究院) | Interpenetrating network hydrogel used as medical implant material and preparation method and application thereof |
| CN114796620B (en)* | 2022-04-24 | 2023-09-29 | 广东顺德工业设计研究院(广东顺德创新设计研究院) | An interpenetrating network hydrogel used as a medical implant material and its preparation method and application |
| CN115634314A (en)* | 2022-10-28 | 2023-01-24 | 广州贝奥吉因生物科技股份有限公司 | Non-supported bone repair gel microsphere and preparation method thereof |
| CN115634314B (en)* | 2022-10-28 | 2023-08-04 | 广州贝奥吉因生物科技股份有限公司 | Unsupported bone repair gel microsphere and preparation method thereof |
| CN118806980A (en)* | 2024-09-18 | 2024-10-22 | 吉林省海卓生物科技有限公司 | Antibacterial modified sodium alginate aerogel hemostatic dressing and preparation method thereof |
Similar Documents
| Publication | Publication Date | Title |
|---|---|---|
| CN110917392B (en) | Hemostatic and antibacterial hydrogel with adhesiveness and preparation method thereof | |
| CN110917391A (en) | Polypeptide modified sodium alginate/PVA hydrogel dressing and preparation method thereof | |
| Lu et al. | A novel in situ‐formed hydrogel wound dressing by the photocross‐linking of a chitosan derivative | |
| CN111675789B (en) | Polydopamine-heparin/quaternary ammonium salt/polyacrylamide hydrogel and preparation | |
| CN111154149A (en) | A kind of hydrogel and its preparation method and dressing | |
| CN106512064B (en) | skin wound dressing with antibacterial performance and preparation method thereof | |
| CN108484936B (en) | Hydrogel prepared from graft modified material and preparation method and application thereof | |
| CN112876694A (en) | Preparation method and application of acrylic acid/epsilon-polylysine adhesive antibacterial hydrogel | |
| CN111166931A (en) | Methacrylic acid sericin/chitosan quaternary ammonium salt hydrogel and preparation method and application thereof | |
| CN113509591A (en) | Antibacterial cationic injectable hydrogel dressing and preparation method thereof | |
| CN112675353A (en) | Recombinant collagen dressing and preparation method thereof | |
| US4778825A (en) | Macrophage stimulation by quadrol | |
| CN112587726B (en) | Composite hydrogel stent and preparation method and application thereof | |
| CN112472867A (en) | Antibacterial medical hydrogel dressing and preparation method thereof | |
| CN119754018B (en) | A composite fiber antibacterial bandage and preparation method thereof | |
| CN120037453A (en) | Antibacterial and antioxidant bionic hydrogel, preparation method and application | |
| CN113209361B (en) | Biological material composite hydrogel wound dressing and preparation method thereof | |
| CN119139537A (en) | Sodium alginate hydrogel dressing with high water absorption rate and application | |
| CN119113193A (en) | An antibacterial and antioxidant composite hydrogel and its preparation method and application | |
| CN118718076A (en) | A nanocomposite hydrogel dressing and preparation method thereof | |
| CN112007201A (en) | Adhesive antibacterial hemostatic sponge and preparation method thereof | |
| CN115558128B (en) | A hydrogel dressing with peroxidase activity and its preparation method and application | |
| CN116099038A (en) | Bioactive hydrogel and preparation method thereof | |
| CN110507846B (en) | A kind of preparation method of long-acting antibacterial and healing-promoting keratin dressing | |
| US20220378976A1 (en) | Means for use in preparation of hydrogel based on hydroxyphenyl derivative of hyaluronan, method of hydrogel preparation and use thereof |
Legal Events
| Date | Code | Title | Description |
|---|---|---|---|
| PB01 | Publication | ||
| PB01 | Publication | ||
| SE01 | Entry into force of request for substantive examination | ||
| SE01 | Entry into force of request for substantive examination | ||
| RJ01 | Rejection of invention patent application after publication | ||
| RJ01 | Rejection of invention patent application after publication | Application publication date:20200327 |